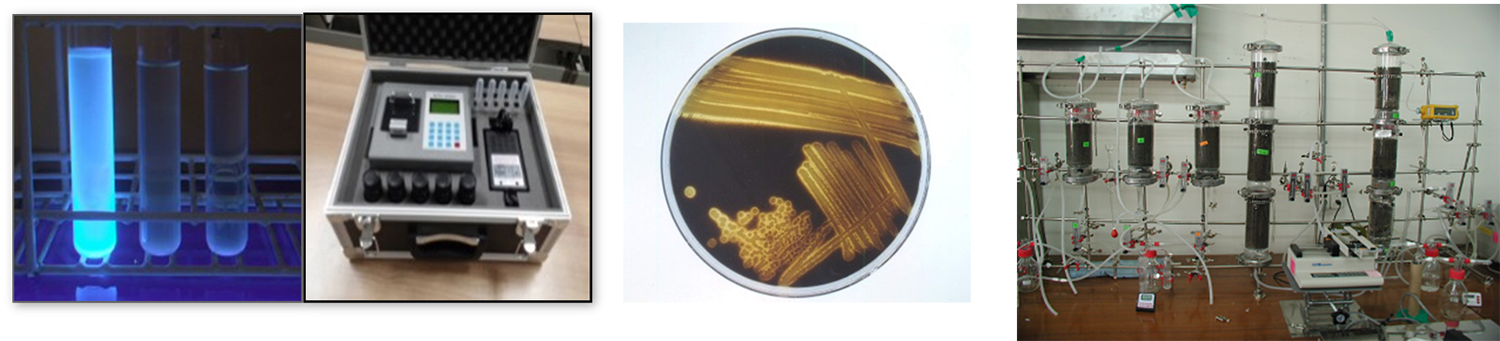

환경미생물학실험실
Environmental Microbiology Lab.
- 지도교수
- 최성찬 교수님
-
지도교수
주요 경력 -
- 2023. 7 ~ 현재, 한림대학교 부총장
- 2012. 3 ~ 2022. 6, 한림대학교 교무처장, 연구처장, 산학협력단장, 기획처장, 학생처장
- 2014. 7 ~ 현재, 강원도 환경분쟁조정위원회 위원
- 1994. 7 ~ 2017. 12, 춘천시 도시계획위원회 위원
- 위치
- 생명과학관 8534호
- 연구분야
-
- 조류대번식 조사 및 대응기술 연구
- 미생물을 이용한 중금속의 약/무독화 반응 연구
- 수도관 생물막 형성 분석과 저감기술 개발
실험실 소개
미생물에 의한 환경오염의 원인 규명과 대응 및 생물학적 정화 기술에 관련한 연구를 수행하고 있습니다.